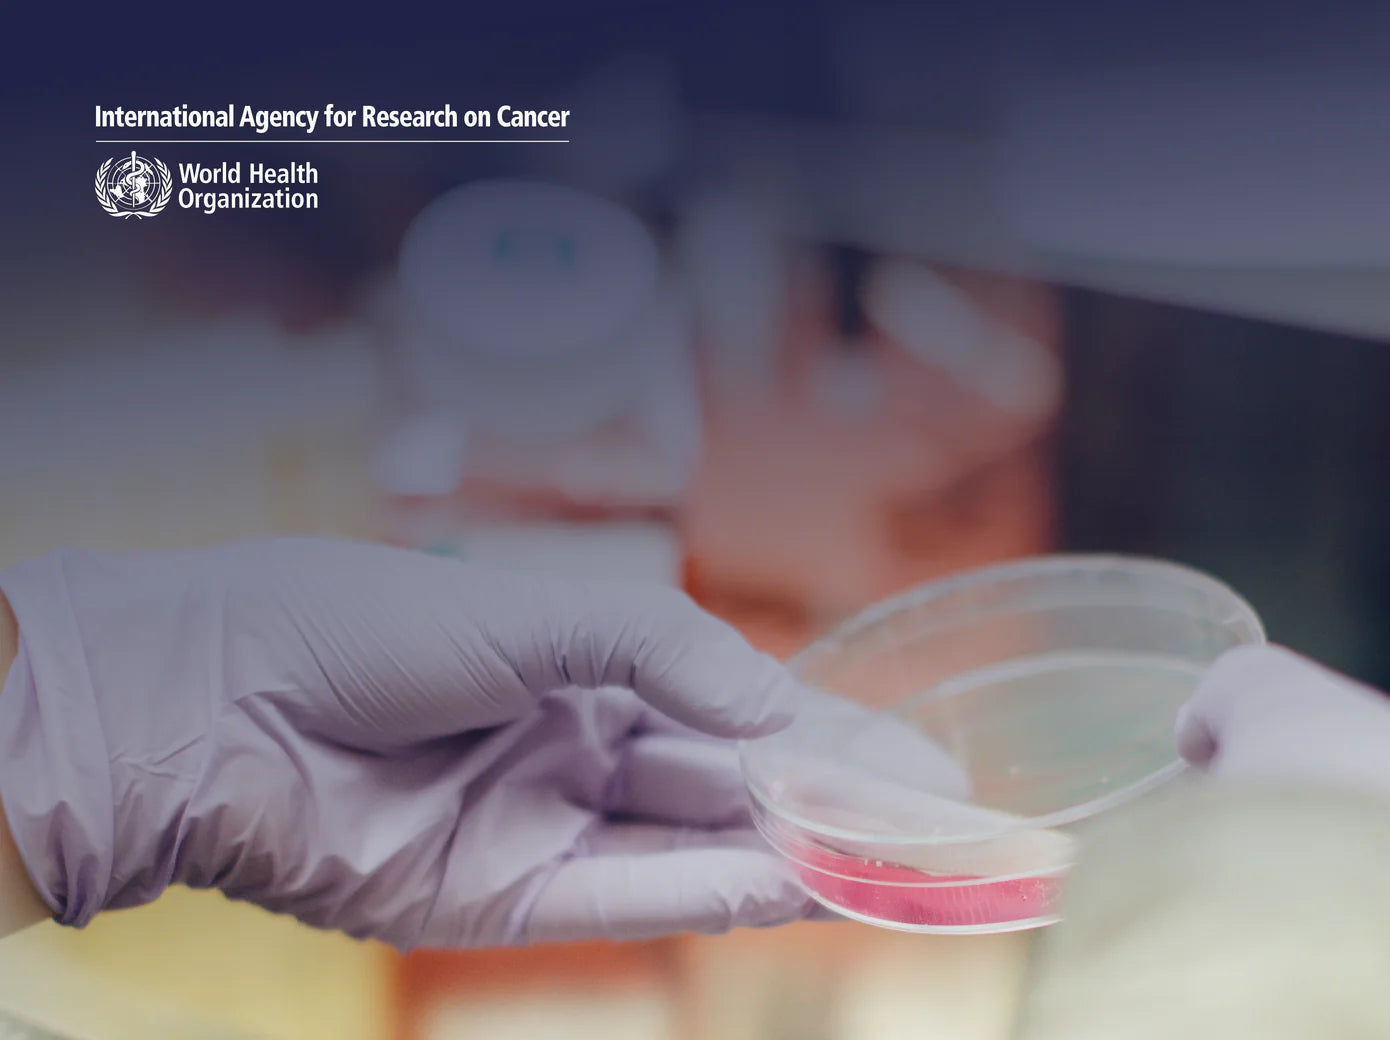

Reimpostare la password
Vi invieremo un'e-mail per reimpostare la password.
Carrello della spesa ()
Queste sono le taglie per una vestibilità perfetta. Le nostre taglie italiane potrebbero variare rispetto a quelle a cui siete abituati e risultare un po' più piccole rispetto alle vostre taglie personalizzate.
Uomo
| Taglia (IT) | Vita | ||||
|---|---|---|---|---|---|
| INCH | CM | CM | |||
| S | 26-28 | 36-38 | 72-76 | ||
| M | 30-32 | 40-42 | 80-84 | ||
| L | 34-36 | 44-46 | 88-92 | ||
| XL | 38-40 | 48-50 | 96-100 | ||
| 2XL | 42-44 | 52-54 | 104-108 | ||
| 3XL | 46-48 | 56-58 | 112-116 | ||
Bambini
| 2 Anni | 4 Anni | 6 Anni | 8 Anni |
|---|---|---|---|
| 92 cm | 104 cm | 116 cm | 128 cm |
| 10 Anni | 12 Anni | 14 Anni | 16 Anni |
| 140 cm | 152 cm | 164 cm | 176 cm |
Imballaggio Mcalson
Questi sono i nostri involucri di cartone che vengono posizionati attorno alla scatola dei boxer per una presentazione e una protezione aggiuntive. Sono disponibili in una varietà di design unici, migliorando l'aspetto e la sensazione complessiva dell'imballaggio.
Non includiamo le maniche per ogni boxer, poiché questo graverebbe inutilmente sul pianeta con l'uso della carta. Tuttavia, siamo molto orgogliosi delle nostre maniche, quindi sentiti libero di richiederle qui.
Avete aggiunto boxer di diverse taglie. È corretto?







